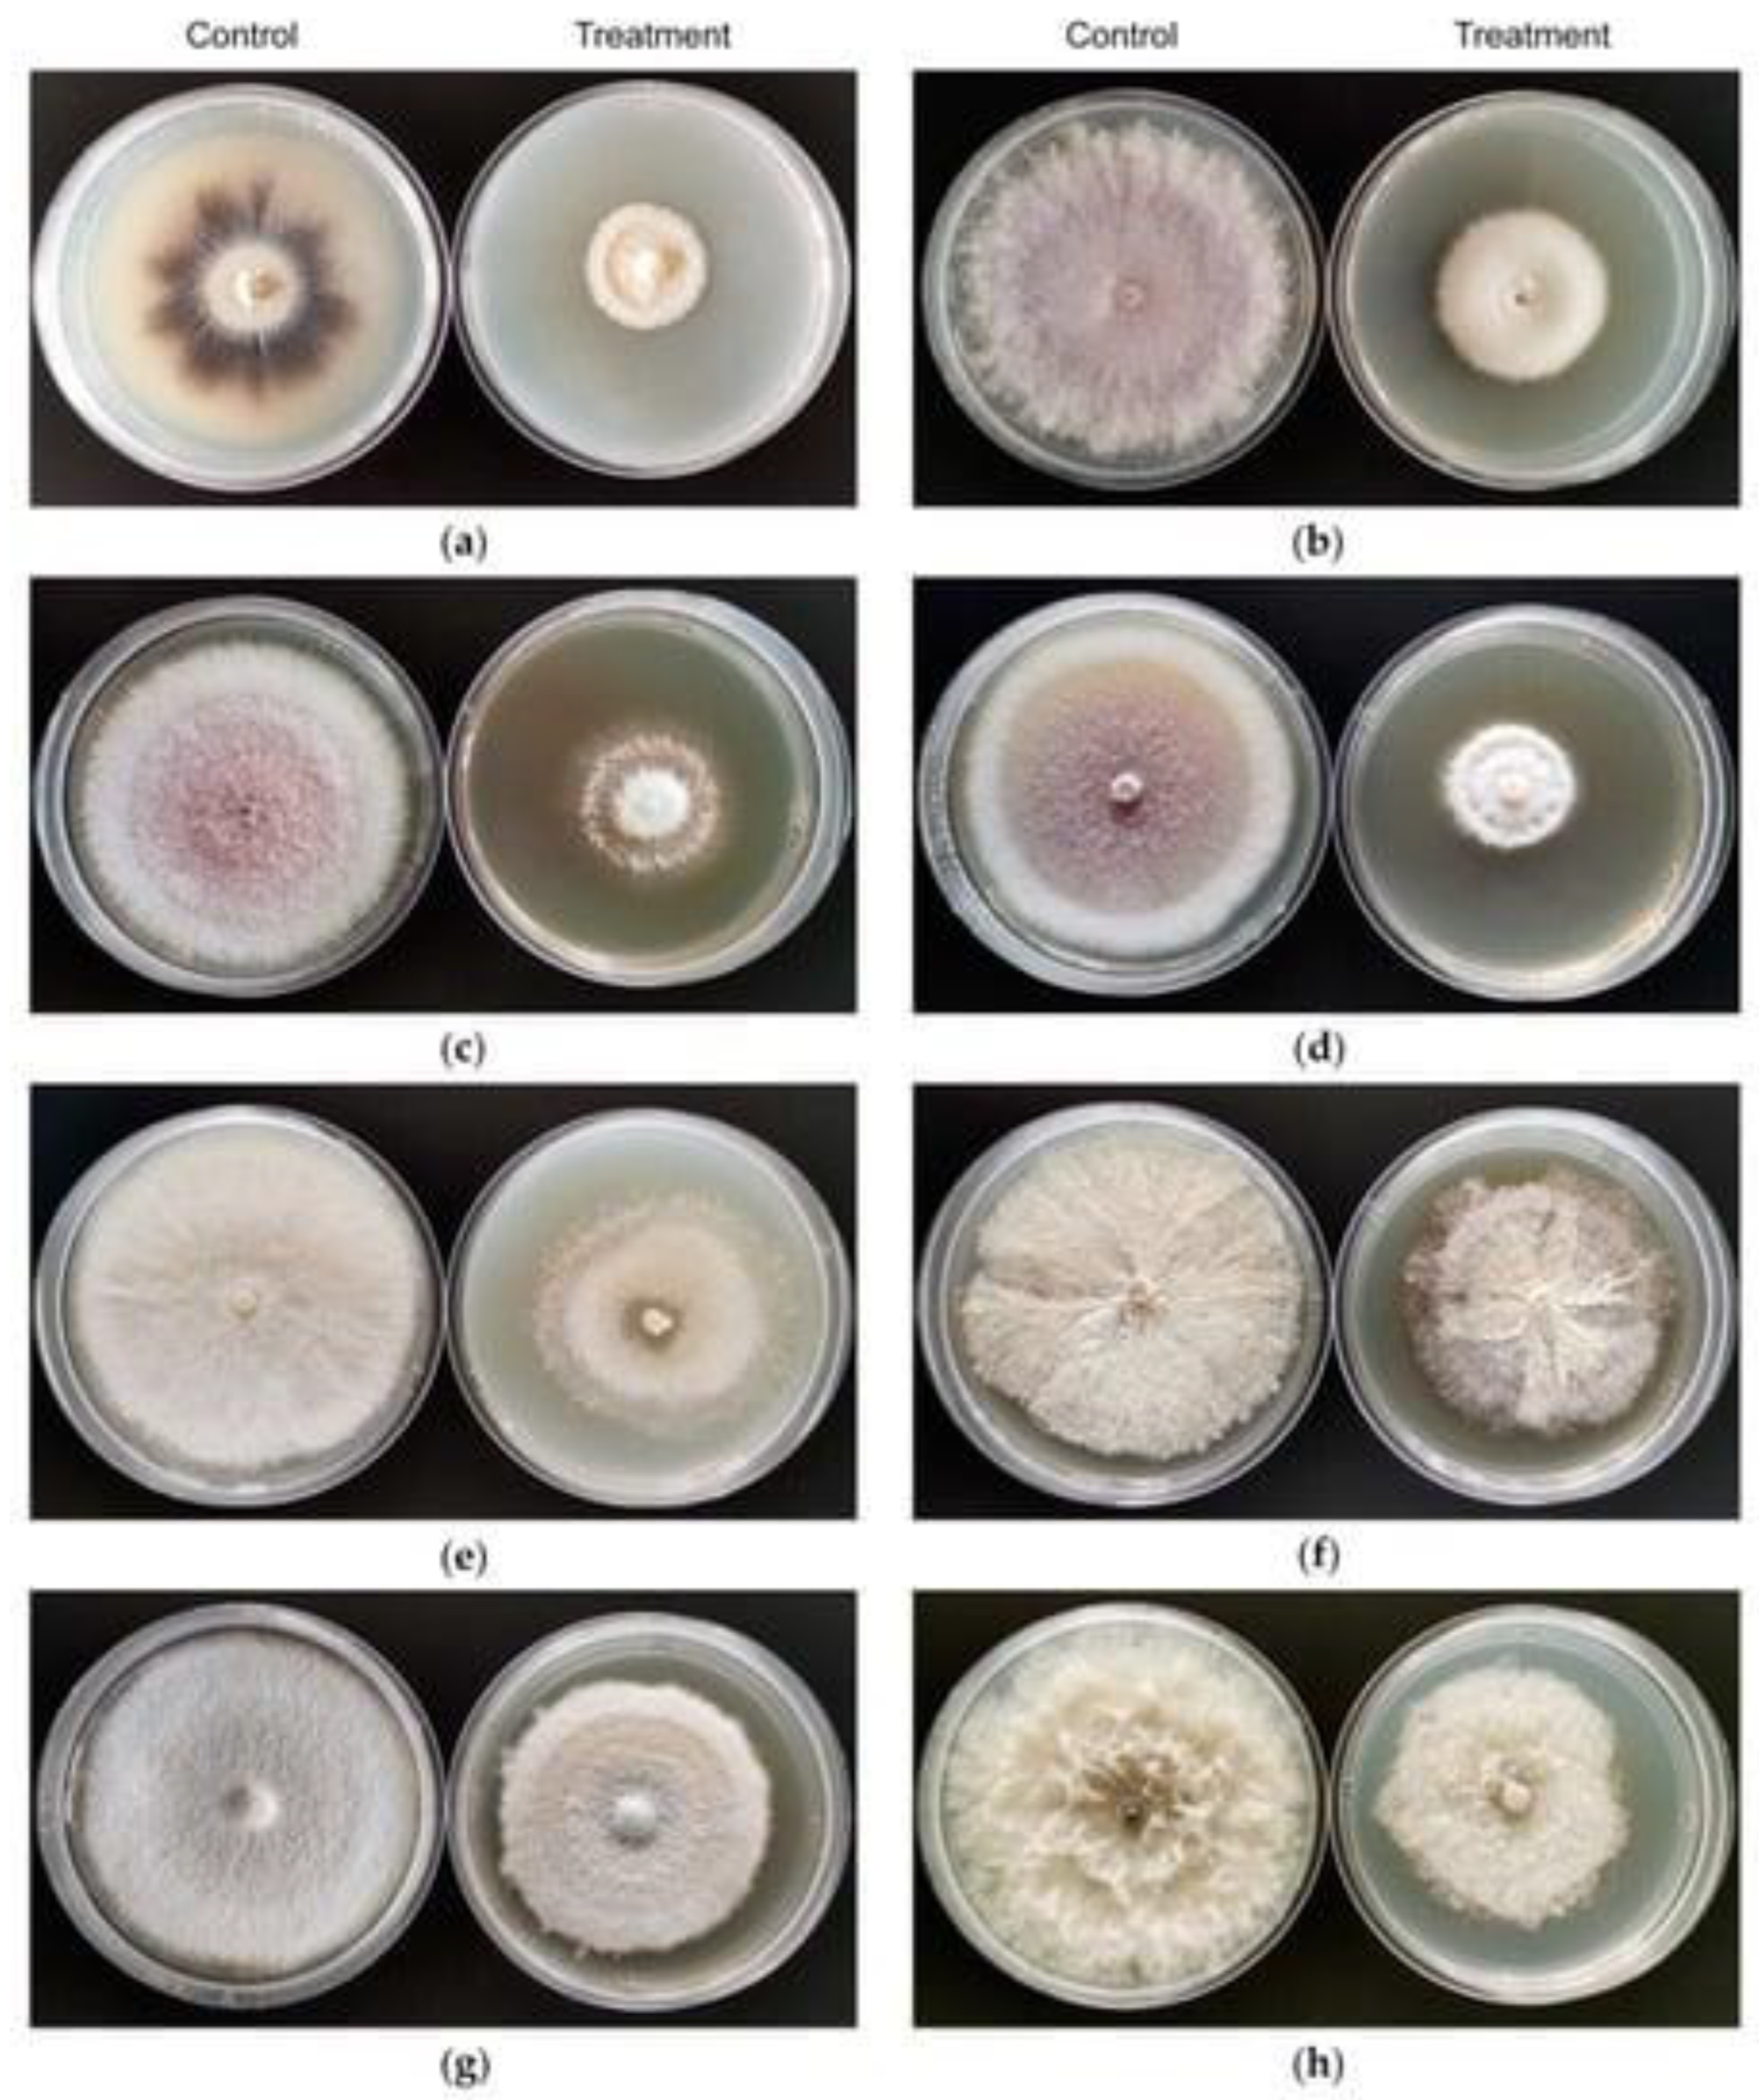
Jof 08 01288 g003 Jof 08 01288 g003

Lysinibacilli: A Biological Factories Intended for Bio-Insecticidal, Bio-Control, and Bioremediation Activities
Abstract
1. Introduction
2. Insecticidal Potential of Lysinibacillus
3. Antibacterial and Antifungal Potential of Lysinibacillus
4. Metal Remediation Potential of Lysinibacillus
5. Plant Protection as Well as Plant Growth Promoter Potential of Lysinibacillus against Bacteria and Fungi
6. Conclusions
Author Contributions
Funding
Institutional Review Board Statement
Informed Consent Statement
Data Availability Statement
Acknowledgments
Conflicts of Interest
References
- Thomas, S.; Izard, J.; Walsh, E.; Batich, K.; Chongsathidkiet, P.; Clarke, G.; Sela, D.A.; Muller, A.J.; Mullin, J.M.; Albert, K.; et al. The host microbiome regulates and maintains human health: A Primer and perspective for Non-Microbiologists. Cancer Res. 2017, 77, 1783–1812. [Google Scholar] [CrossRef] [PubMed]
- Kwiatkowski, S.; Polat, M.; Yu, W.; Johnson, M.S. Industrial Emissions Control Technologies: Introduction. In Air Pollution Sources, Statistics and Health Effects; Springer: Berlin/Heidelberg, Germany, 2020; pp. 477–511. [Google Scholar]
- Ahmad, V.; Khan, M.S.; Jamal, Q.M.; Alzohairy, M.A.; Al Karaawi, M.A.; Siddiqui, M.U. Antimicrobial potential of bacteriocins: In therapy, agriculture and Food Preservation. Int. J. Antimicrob. Agents 2017, 49, 1–11. [Google Scholar] [CrossRef] [PubMed]
- Gibbons, S.M.; Gilbert, J.A. Microbial diversity—Exploration of natural ecosystems and microbiomes. Curr. Opin. Genet. Dev. 2015, 35, 66–72. [Google Scholar] [CrossRef] [PubMed]
- Bravo, A.; Likitvivatanavong, S.; Gill, S.S.; Soberón, M. Bacillus thuringiensis: A story of a successful bioinsecticide. Insect Biochem. Mol. Biol. 2011, 41, 423–431. [Google Scholar] [CrossRef]
- Ahmad, V.; Kamal, A.; Ahmad, K.; Khan, M.S. Protease characteristics of bacteriocin producing lysinibacilli, isolated from fruits and vegetable waste. Bioinformation 2014, 10, 13–18. [Google Scholar] [CrossRef][Green Version]
- Ahmad, V.; Muhammad Zafar Iqbal, A.N.; Haseeb, M.; Khan, M.S. Antimicrobial potential of bacteriocin producing Lysinibacillus JX416856 against foodborne bacterial and fungal pathogens, isolated from fruits and vegetable waste. Anaerobe 2014, 27, 87–95. [Google Scholar] [CrossRef]
- Junaid, J.M.; Dar, N.A.; Bhat, T.A.; Bhat, A.H.; Bhat, M.A. Commercial biocontrol agents and their mechanism of action in the management of plant pathogens. Int. J. Mod. Plant Anim. 2013, 1, 39–57. [Google Scholar]
- Kandler, C.; Weiss, N. The Genus Lactobacillus. In Bergey’s Manual of Systematic Bacteriology; Sneath, P.H.A., Mair, N.S., Sharpe, M.E., Holt, J.G., Eds.; Academic Press: London, UK, 1986; p. 1209. [Google Scholar]
- Zhang, H.; Liu, L.; Hao, Y.; Zhong, S.; Liu, H.; Han, T.; Xie, Y. Isolation and partial characterization of a bacteriocin produced by lactobacillus plantarum BM-1 isolated from a traditionally fermented Chinese meat product. Microbiol. Immunol. 2013, 57, 746–755. [Google Scholar] [CrossRef]
- Hayat, R.; Iftikhar, A.; Peak, J.; Ehsan, M.E. A moderately boron tolerant candidatus novel soil bacterium Lysinibacillus pakistanensis sp. nov. cand., isolated from soybean (Glycine max. L) rhizosphere. Pak. J. Bot 2013, 45, 41–50. [Google Scholar]
- Hofvendahl, K.; van Niel, E.W.; Hahn-Hägerdal, B. Effect of temperature and ph on growth and product formation of Lactococcus lactis SSP. LACTIS ATCC 19435 growing on maltose. Appl. Microbiol. Biotechnol. 1999, 51, 669–672. [Google Scholar] [CrossRef][Green Version]
- Ryu, Y.; Hong, M.; Kim, S.B.; Lee, T.K.; Park, W. Raman spectroscopy reveals alteration of spore compositions under different nutritional conditions in Lysinibacillus boronitolerans YS11. J. Microbiol. 2021, 59, 491–499. [Google Scholar] [CrossRef] [PubMed]
- Biswas, S.R.; Ray, P.; Johnson, M.C.; Ray, B. Influence of growth conditions on the production of a bacteriocin, Pediocin Ach, by pediococcus acidilactici H. Appl. Environ. Microbiol. 1991, 57, 1265–1267. [Google Scholar] [CrossRef]
- Ahmed, I.; Sin, Y.; Paek, J.; Ehsan, M.; Hayat, R.; Iqbal., M.; Hyo, Y. Description of Lysinibacillu spakistanensis. Int. J. Agric. Biol. 2014, 16, 447–450. [Google Scholar]
- Smibert, R.M.; Krieg, N.R. Phenotypic characterization. In Methods for General and Molecular Bacteriology; Gerhardt, P., Murray, R.G.E., Wood, W.A., Krieg, N.R., Eds.; American Society for Microbiology: Washington, DC, USA, 1994; pp. 607–654. [Google Scholar]
- Seiler, H.; Scherer, S.; Wenning, M. Lysinibacillus meyeri sp. nov., isolated from a medical practice. Int. J. Syst. Evol. Microbiol. 2013, 63, 1512–1518. [Google Scholar] [CrossRef]
- Wang, J.; Fan, Y.; Yao, Z. Isolation of a Lysinibacillus fusiformis strain with tetrodotoxin-producing ability from puffer fish fugu obscurus and the characterization of this strain. Toxicon 2010, 56, 640–643. [Google Scholar] [CrossRef]
- Rodrigues, G.C.; dos Santos Maia, M.; Cavalcanti, A.B.; de Sousa, N.F.; Scotti, M.T.; Scotti, L. In silico studies of Lamiaceae diterpenes with bioinsecticide potential against Aphis gossypii and drosophila melanogaster. Molecules 2021, 26, 766. [Google Scholar] [CrossRef] [PubMed]
- Şengül Demirak, M.Ş.; Canpolat, E. Plant-based Bioinsecticides for mosquito control: Impact on insecticide resistance and disease transmission. Insects 2022, 13, 162. [Google Scholar] [CrossRef]
- Cheng, M.; Zhang, H.; Zhang, J.; Hu, G.; Zhang, J.; He, J.; Huang, X. Lysinibacillus fluoroglycofenilyticus sp. nov., a bacterium isolated from fluoroglycofen contaminated soil. Antonie Van Leeuwenhoek 2015, 107, 157–164. [Google Scholar] [CrossRef] [PubMed]
- Baumann, P.; Clark, M.A.; Baumann, L.; Broadwell, A.H. Bacillus sphaericus as a mosquito pathogen: Properties of the organism and its toxins. Microbiol. Rev. 1991, 55, 425–436. [Google Scholar] [CrossRef] [PubMed]
- Kellen, W.R.; Clark, T.B.; Lindegren, J.E.; Ho, B.C.; Rogoff, M.H.; Singer, S. Bacillus sphaericus Neide as a pathogen of mosquitoes. J. Invertebr. Pathol. 1965, 7, 442–448. [Google Scholar] [CrossRef]
- Fillinger, U.; Knols, B.G.; Becker, N. Efficacy and efficiency of new bacillus thuringiensis var. Israelensis and bacillus sphaericus formulations against Afrotropical anophelines in western Kenya. Trop. Med. Int. Health 2003, 8, 37–47. [Google Scholar] [CrossRef] [PubMed]
- Siegel, J.P.; Novak, R.J. Duration of activity of the microbial larvicide VectoLex CG (Bacillus sphaericus) in Illinois catch basins and waste tires. J. Am. Mosq. Control Assoc. 1999, 15, 366–370. [Google Scholar] [PubMed]
- Berry, C. The bacterium, Lysinibacillus sphaericus, as an insect pathogen. J. Invertebr. Pathol. 2012, 109, 1–10. [Google Scholar] [CrossRef] [PubMed]
- Nishiwaki, H.; Nakashima, K.; Ishida, C.; Kawamura, T.; Matsuda, K. Cloning, functional characterization, and mode of action of a novel insecticidal pore-forming toxin, Sphaericolysin, produced by bacillus sphaericus. Appl. Environ. Microbiol. 2007, 73, 3404–3411. [Google Scholar] [CrossRef]
- Guo, Q.; Gao, Y.; Xing, C.; Ding, L.; Dai, X.; Xie, Q.; Tan, X. The cry48aa N-terminal domain is responsible for cry48aa–cry49aa interaction in Lysinibacillus sphaericus toxin. Curr. Microbiol. 2020, 77, 1217–1222. [Google Scholar] [CrossRef]
- Rungrod, A.; Tjahaja, N.K.; Soonsanga, S.; Audtho, M.; Promdonkoy, B. Bacillus sphaericus mtx1 and MTX2 toxins co-expressed in Escherichia coli are synergistic against Aedes aegypti larvae. Biotechnol. Lett. 2008, 31, 551–555. [Google Scholar] [CrossRef] [PubMed]
- Kanwal, S.; Abeysinghe, S.; Srisaisup, M.; Boonserm, P. Cytotoxic effects and intracellular localization of bin toxin from Lysinibacillus sphaericus in human liver cancer cell line. Toxins 2021, 13, 288. [Google Scholar] [CrossRef]
- Chankamngoen, W.; Janvilisri, T.; Promdonkoy, B.; Boonserm, P. In vitro analysis of the anticancer activity of Lysinibacillus sphaericus binary toxin in human cancer cell lines. 3 Biotech 2020, 10, 365. [Google Scholar] [CrossRef] [PubMed]
- Ahsan, N.; Shimizu, M. lysinibacillus species: Their potential as effective bioremediation, Biostimulant, and Biocontrol Agents. Rev. Agric. Sci. 2021, 9, 103–116. [Google Scholar] [CrossRef] [PubMed]
- Trakulnaleamsai, C.; Promdonkoy, B.; Soonsanga, S. Production of Lysinibacillus sphaericus mosquitocidal protein MTX2 from bacillus subtilis as a secretory protein. Protein Pept. Lett. 2021, 28, 1054–1060. [Google Scholar] [CrossRef]
- Bernal, L.; Dussán, J. Synergistic effect of Lysinibacillus sphaericus and glyphosate on Temephos-resistant larvae of Aedes aegypti. Parasites Vectors 2020, 13, 68. [Google Scholar] [CrossRef] [PubMed]
- Saied, E.; Fouda, A.; Alemam, A.M.; Sultan, M.H.; Barghoth, M.G.; Radwan, A.A.; Desouky, S.G.; Azab, I.H.; Nahhas, N.E.; Hassan, S.E.-D. Evaluate the toxicity of pyrethroid insecticide Cypermethrin before and after biodegradation by Lysinibacillus cresolivuorans strain HIS7. Plants 2021, 10, 1903. [Google Scholar] [CrossRef] [PubMed]
- Karthick, P.; Mohanraju, R. Antimicrobial compounds produced by Lysinibacillus odysseyi epiphytic bacteria associated with red algae. Braz. J. Microbiol. 2020, 51, 1683–1690. [Google Scholar] [CrossRef]
- Onajobi, I.B.; Idowu, E.O.; Adeyemi, J.O.; Samson, O.J.; Ogunyinka, P.I.; Fagade, O.E. In vitro antibacterial activities and molecular characterization of bacterial species isolated from farmlands against selected pathogens. Biotechnol. Rep. 2020, 27, e00513. [Google Scholar] [CrossRef]
- Ahmad, V.; Ahmad, K.; Baig, M.H.; AL-Shwaiman, H.A.; Al Khulaifi, M.M.; Elgorban, A.M.; Khan, M.S. Efficacy of a novel bacteriocin isolated from Lysinibacillus sp. against Bacillus pumilus. LWT 2019, 102, 260–267. [Google Scholar] [CrossRef]
- Maela, M.P.; van der Walt, H.; Serepa-Dlamini, M.H. The antibacterial, antitumor activities, and bioactive constituents’ identification of ALECTRA sessiliflora bacterial endophytes. Front. Microbiol. 2022, 13, 870821. [Google Scholar] [CrossRef] [PubMed]
- Che, J.; Liu, B.; Liu, G.; Chen, Q.; Lan, J. Volatile organic compounds produced by lysinibacillus sp. Fjat-4748 possess antifungal activity against Colletotrichum acutatum. Biocontrol. Sci. Technol. 2017, 27, 1349–1362. [Google Scholar] [CrossRef]
- Shabanamol, S.; Thampi, M.; Sajana, P.; Varghese, S.; Karthika, S.; George, T.K.; Jisha, M.S. Characterization of the major antifungal extrolite from rice endophyte Lysinibacillus sphaericus against Rhizoctonia solani. Arch. Microbiol. 2021, 203, 2605–2613. [Google Scholar] [CrossRef]
- Passera, A.; Rossato, M.; Oliver, J.S.; Battelli, G.; Shahzad, G.-I.-R.; Cosentino, E.; Sage, J.M.; Toffolatti, S.L.; Lopatriello, G.; Davis, J.R.; et al. Characterization of Lysinibacillus fusiformis strain S4C11: In vitro, in planta, and in silico analyses reveal a plant-beneficial microbe. Microbiol. Res. 2021, 244, 126665. [Google Scholar] [CrossRef]
- Kamaruzzaman, M.A.; Abdullah, S.R.S.; Hasan, H.A.; Hassan, M.; Othman, A.R.; Idris, M. Characterisation of PB-resistant plant growth-promoting rhizobacteria (PGPR) from Scirpus grossus. Biocatal. Agric. Biotechnol. 2020, 23, 101456. [Google Scholar] [CrossRef]
- Sharma, N.; Saharan, B.S. Role of Lysinibacillus sphaericus SNCh5 Bacterial Strain as Bio-inoculant for Agriculture Practice. Int. J. Curr. Microbiol. App. Sci. 2015, 4, 484–499. [Google Scholar]
- Park, M.; Kim, C.; Yang, J.; Lee, H.; Shin, W.; Kim, S.; Sa, T. Isolation and characterization of diazotrophic growth promoting bacteria from rhizosphere of agricultural crops of Korea. Microbiol. Res. 2005, 160, 127–133. [Google Scholar] [CrossRef] [PubMed]
- Singh, R.K.; Kumar, D.P.; Solanki, M.K.; Singh, P.; Srivastva, A.K.; Kumar, S.; Kashyap, P.L.; Saxena, A.K.; Singhal, P.K.; Arora, D.K. Optimization of media components for chitinase production by chickpea rhizosphere associated Lysinibacillus fusiformis B-CM18. J. Basic Microbiol. 2012, 53, 451–460. [Google Scholar] [CrossRef]
- Islam, M.R.; Sultana, T.; Joe, M.M.; Yim, W.; Cho, J.-C.; Sa, T. Nitrogen-fixing bacteria with multiple plant growth-promoting activities enhance growth of tomato and Red Pepper. J. Basic Microbiol. 2013, 53, 1004–1015. [Google Scholar] [CrossRef] [PubMed]
- Martínez, S.A.; Dussán, J. Lysinibacillus sphaericus plant growth promoter bacteria and lead phytoremediation enhancer with Canavalia ensiformis. Environ. Prog. Sustain. Energy 2017, 37, 276–282. [Google Scholar] [CrossRef]
- Borah, A.; Das, R.; Mazumdar, R.; Thakur, D. Culturable endophytic bacteria of camellias pecies endowed with plant growth promoting characteristics. J. Appl. Microbiol. 2019, 127, 825–844. [Google Scholar] [CrossRef]
- Abiala, M.A.; Odebode, A.C.; Hsu, S.F.; Blackwood, C.B. Phytobeneficial properties of bacteria isolated from the rhizosphere of maize in southwestern Nigerian soils. Appl. Environ. Microbiol. 2015, 81, 4736–4743. [Google Scholar] [CrossRef]
- Labuschagne, N.; Hassen, A.I.; Pretorius, T. Plant Growth Promoting Rhizobacterial Strains and Their Uses. WO2015114552A1, 6 August 2015. [Google Scholar]
- Verma, P.; Yadav, A.N.; Khannam, K.S.; Kumar, S.; Saxena, A.K.; Suman, A. Molecular diversity and multifarious plant growth promoting attributes of Bacilli associated with wheat (Triticum aestivum L.) rhizosphere from six diverse agro-ecological zones of India. J. Basic Microbiol. 2015, 56, 44–58. [Google Scholar] [CrossRef]
- Vendan, R.T.; Yu, Y.J.; Lee, S.H.; Rhee, Y.H. Diversity of endophytic bacteria in ginseng and their potential for plant growth promotion. J. Microbiol. 2010, 48, 559–565. [Google Scholar] [CrossRef]
- Trivedi, P.; Spann, T.; Wang, N. Isolation and characterization of beneficial bacteria associated with citrus roots in Florida. Microb. Ecol. 2011, 62, 324–336. [Google Scholar] [CrossRef]
- Naureen, Z.; Rehman, N.U.; Hussain, H.; Hussain, J.; Gilani, S.A.; Al Housni, S.K.; Mabood, F.; Khan, A.L.; Farooq, S.; Abbas, G.; et al. Exploring the potentials of Lysinibacillus sphaericus za9 for plant growth promotion and biocontrol activities against phytopathogenic fungi. Front. Microbiol. 2017, 8, 1477. [Google Scholar] [CrossRef] [PubMed]
- Rahmoune, B.; Morsli, A.; Khelifi-Slaoui, M.; Khelifi, L.; Strueh, A.; Erban, A.; Kopka, J.; Prell, J.; van Dongen, J.T. Isolation and characterization of three new PGPR and their effects on the growth of Arabidopsis and Datura plants. J. Plant Interact. 2016, 12, 1–6. [Google Scholar] [CrossRef]
- Duo, L.A.; Liu, C.X.; Zhao, S.L. Alleviation of drought stress in turfgrass by the combined application of nano-compost and microbes from compost. Russ. J. Plant Physiol. 2018, 65, 419–426. [Google Scholar] [CrossRef]
- Abdel-Salam, M.S.; Ameen, H.H.; Soliman, G.M.; Elkelany, U.S.; Asar, A.M. Improving the nematicidal potential of Bacillus amyloliquefaciens and Lysinibacillus sphaericus against the root-knot nematode meloidogyne incognita using protoplast fusion technique. Egypt. J. Biol. Pest Control 2018, 28, 31. [Google Scholar] [CrossRef]
- Sule, I.O.; Okonye, T.O.; Hassan, M. Enhancement of growth of potted maize plants using Aspergillus niger and Lysinibacillus sphaericus. Annals. Food Sci. Tech. 2020, 21, 233–242. [Google Scholar]
- Kumar Sahu, P.; Shivaprakash, M.K.; Karaba, N.; Mallesha, B.C.; Subbarayappa, C.T.; Brahmaprakash, G.P. Effect of bacterial endophytes lysinibacillus sp. on plant growth and fruit yield of tomato (Solanum lycopersicum). Int. J. Curr. Microbiol. Appl. Sci. 2018, 7, 3399–3408. [Google Scholar] [CrossRef]
- Sgroy, V.; Cassán, F.; Masciarelli, O.; Del Papa, M.F.; Lagares, A.; Luna, V. Isolation and characterization of Endophytic Plant Growth-promoting (PGPB) or stress homeostasis-regulating (PSHB) bacteria associated to the halophyte Prosopis strombulifera. Appl. Microbiol. Biotechnol. 2009, 85, 371–381. [Google Scholar] [CrossRef]
- Kumar, K.; Amaresan, N.; Madhuri, K. Alleviation of the adverse effect of salinity stress by inoculation of plant growth promoting rhizobacteria isolated from hot humid tropical climate. Ecol. Eng. 2017, 102, 361–366. [Google Scholar] [CrossRef]
- Pal, A.K.; Sengupta, C. Isolation of Cadmium and Lead Tolerant Plant Growth Promoting Rhizobacteria: Lysinibacillus varians and Pseudomonas putida from Indian Agricultural Soil. Soil Sediment Contam. 2019, 28, 601–629. [Google Scholar] [CrossRef]
- Jinal, H.N.; Gopi, K.; Prittesh, P.; Kartik, V.P.; Amaresan, N. Phytoextraction of iron from contaminated soils by inoculation of iron-tolerant plant growth-promoting bacteria in Brassica juncea L. Czern. Environ. Sci. Pollut. Res. 2019, 26, 32815–32823. [Google Scholar] [CrossRef]
- De Mandal, S.; Singh, S.S.; Kumar, N.S. Analyzing plant growth promoting Bacillus sp. and related genera in Mizoram, Indo-Burma Biodiversity Hotspot. Biocatal. Agric. Biotechnol. 2018, 15, 370–376. [Google Scholar] [CrossRef]
- Khadka, S.; Adhikari, S.; Thapa, A.; Panday, R.; Adhikari, M.; Sapkota, S.; Regmi, R.S.; Adhikari, N.P.; Proshad, R.; Koirala, N. Screening and optimization of newly isolated thermotolerant Lysinibacillus fusiformis strain SK for protease and antifungal activity. Curr. Microbiol. 2020, 77, 1558–1568. [Google Scholar] [CrossRef] [PubMed]
- Masri, M.; Sukmawaty, E.; Awalia Amir, A. Anti fungal activity of chitinolytic bacteria Lysinibacillus fusiformis and Brevibacillus reuszeri against the fungal pathogens Rhizoctonia solani and Fusarium oxysporum. Microbiol. Indones. 2022, 15, 3. [Google Scholar] [CrossRef]
- El-Sayed, S.E.; Abdelaziz, N.A.; Osman, H.-E.; El-Housseiny, G.S.; Aleissawy, A.E.; Aboshanab, K.M. Lysinibacillus isolate mk212927: A natural producer of allylamine antifungal ‘terbinafine. Molecules 2021, 27, 201. [Google Scholar] [CrossRef] [PubMed]
- Li, X.; Wang, X.; Shi, X.; Wang, B.; Li, M.; Wang, Q.; Zhang, S. Antifungal effect of volatile organic compounds from bacillus velezensis CT32 against Verticillium dahliae and Fusarium oxysporum. Processes 2020, 8, 1674. [Google Scholar] [CrossRef]
- Oldfield, F.; Dearing, J.A. The role of human activities in past environmental change. In Paleoclimate, Global Change and the Future; Springer: Berlin/Heidelberg, Germany, 2003; pp. 143–162. [Google Scholar]
- Shetty, K.; Krishnakumar, G. Algal and cyanobacterial biomass as potential Dye biodecolorizing material: A Review. Biotechnol. Lett. 2020, 42, 2467–2488. [Google Scholar] [CrossRef]
- Atkinson, B.W.; Bux, F.; Kasan, H.C. Considerations for application of biosorption technology to remediatemetal-contaminated industrial effluents. Water South Afr. 1998, 24, 129–135. [Google Scholar]
- Mumtaz, M.Z.; Ahmad, M.; Jamil, M.; Hussain, T. Zinc Solubilizing bacillus spp. potential candidates for biofortification in maize. Microbiol. Res. 2017, 202, 51–60. [Google Scholar] [CrossRef]
- Jinal, H.N.; Gopi, K.; Kumar, K.; Amaresan, N. Effect of zinc-resistant lysinibacillus species inoculation on growth, physiological properties, and zinc uptake in maize (Zea mays L.). Environ. Sci. Pollut. Res. 2020, 28, 6540–6548. [Google Scholar] [CrossRef]
- O’Neal, S.L.; Zheng, W. Manganese toxicity upon overexposure: A decade in Review. Curr. Environ. Health Rep. 2015, 2, 315–328. [Google Scholar] [CrossRef]
- Ghosh, S.; Gandhi, M.; van Hullebusch, E.D.; Das, A.P. Proteomic insights into Lysinibacillus sp.-mediated biosolubilization of manganese. Environ. Sci. Pollut. Res. 2020, 28, 40249–40263. [Google Scholar] [CrossRef]
- Compant, S.; Duffy, B.; Nowak, J.; Clément, C.; Barka, E.A. Use of plant growth-promoting bacteria for biocontrol of plant diseases: Principles, mechanisms of action, and future prospects. Appl. Environ. Microbiol. 2005, 71, 4951–4959. [Google Scholar] [CrossRef] [PubMed]
- Zhu, Y.; He, X.; Xu, J.; Fu, Z.; Wu, S.; Ni, J.; Hu, B. Insight into efficient removal of cr(vi) by magnetite immobilized with lysinibacillus sp. JLT12: Mechanism and performance. Chemosphere 2021, 262, 127901. [Google Scholar] [CrossRef] [PubMed]
- Tan, H.; Wang, C.; Zeng, G.; Luo, Y.; Li, H.; Xu, H. Bioreduction and biosorption of cr(vi) by a novel bacillus sp. CRB-B1 strain. J. Hazard. Mater. 2020, 386, 121628. [Google Scholar] [CrossRef] [PubMed]
- Wang, X.; Li, H.; Huang, H.; Luo, H.; Luo, S.; Jiang, L.; Feng, S.; Xu, H. Investigation on mechanism of hexavalent chromium bioreduction by escherichia sp.. th-1 and the stability of reduction products. J. Environ. Chem. Eng. 2022, 10, 107231. [Google Scholar] [CrossRef]
- Peng, H.; Liang, K.; Luo, H.; Huang, H.; Luo, S.; Zhang, A.K.; Xu, H.; Xu, F. A bacillus and Lysinibacillus sp. bio-augmented Festuca arundinacea phytoremediation system for the rapid decontamination of chromium influenced soil. Chemosphere 2021, 283, 131186. [Google Scholar] [CrossRef] [PubMed]
- Chen, J.; Li, X.; Gan, L.; Jiang, G.; Zhang, R.; Xu, Z.; Tian, Y. Mechanism of cr(vi) reduction by Lysinibacillus sp. HST-98, a newly isolated cr (vi)-reducing strain. Environ. Sci. Pollut. Res. 2021, 28, 66121–66132. [Google Scholar] [CrossRef]
- Li, S.-W.; Wen, Y.; Leng, Y. Transcriptome analysis provides new insights into the tolerance and reduction of Lysinibacillus fusiformis 15–4 to hexavalent chromium. Appl. Microbiol. Biotechnol. 2021, 105, 7841–7855. [Google Scholar] [CrossRef]
- Moll, H.; Lehmann, F.; Raff, J. Interaction of curium(iii) with surface-layer proteins from Lysinibacillus sphaericus JG-A12. Colloids Surf. B Biointerfaces 2020, 190, 110950. [Google Scholar] [CrossRef]
- Velásquez, L.; Dussan, J. Biosorption and bioaccumulation of heavy metals on dead and living biomass of bacillus sphaericus. J. Hazard. Mater. 2009, 167, 713–716. [Google Scholar] [CrossRef]
- Mathivanan, K.; Rajaram, R.; Balasubramanian, V. Biosorption of CD(II) and cu(ii) ions using lysinibacillus fusiformis KMNTT-10: Equilibrium and kinetic studies. Desalination Water Treat. 2015, 57, 22429–22440. [Google Scholar] [CrossRef]
- Javier, E.V.; Jenny, D. Adsorption of Toxic Metals and Control of Mosquitos-borne Disease by Lysinibacillus sphaericus: Dual Benefits for Health and Environment. Biomed. Environ. Sci. BES 2016, 29, 187–196. [Google Scholar] [PubMed]
- Mangu, J.C.; Rai, N.; Mandal, A.; Olsson, P.-E.; Jass, J. Lysinibacillus sphaericus mediates stress responses and attenuates arsenic toxicity in Caenorhabditis elegans. Sci. Total Environ. 2022, 835, 155377. [Google Scholar] [CrossRef] [PubMed]
- Bustos, M.; Ibarra, H.; Dussán, J. The golden activity of Lysinibacillus sphaericus: New Insights on gold accumulation and possible nanoparticles biosynthesis. Materials 2018, 11, 1587. [Google Scholar] [CrossRef]
- Páez-Vélez, C.; Castro-Mayorga, J.L.; Dussán, J. Effective gold biosorption by electrospun and electrosprayed bio-composites with immobilized Lysinibacillus sphaericus CBAM5. Nanomaterials 2020, 10, 408. [Google Scholar] [CrossRef]
- Hayat, R.; Ali, S.; Amara, U.; Khalid, R.; Ahmed, I. Soil beneficial bacteria and their role in Plant Growth Promotion: A Review. Ann. Microbiol. 2010, 60, 579–598. [Google Scholar] [CrossRef]
- Bernhard, A. The nitrogen cycle: Processes. Players, and Human. Nat. Educ. Knowl. 2010, 3, 25. [Google Scholar]
- Yadav, A.N.; Kumar, R.; Kumar, S.; Kumar, V.; Sugitha, T.C.K.; Singh, B.; Chauahan, V.S.; Dhaliwal, H.S.; Saxena, A.K. Beneficial microbiomes: Biodiversity and potential biotechnological applications for sustainable agriculture and human health. J. App. Biol. Biotech. 2017, 5, 45–57. [Google Scholar] [CrossRef]
- Patil, P.P.; Prabhu, M.; Mutnuri, S. A novel and sustainable approach for biotransformation of phosphogypsum to calcium carbonate using urease producing Lysinibacillus sphaericus strain GUMP2. Environ. Technol. 2021; 1–14, Online ahead of print. [Google Scholar]
- Bari, R.; Jones, J.D. Role of plant hormones in plant defence responses. Plant Mol. Biol. 2008, 69, 473–488. [Google Scholar] [CrossRef]
- Pandya, N.D.; and Desai, P.V. Screening and Characterization of GA3 producing Pseudomonas monteilii and its impact on plant growth promotion. Int. J. Curr. Microbiol. Appl. Sci. 2014, 3, 110–115. [Google Scholar]
- Arkhipova, T.N.; Veselov, S.U.; Melentiev, A.I.; Martynenko, E.V.; Kudoyarova, G.R. Ability of bacterium Bacillus subtilis to produce cytokinins and to influence the growth and endogenous hormone content of lettuce plants. Plant Soil 2005, 272, 201–209. [Google Scholar] [CrossRef]
- Hanh, H.T.; and Mongkolthanaruk, W. Correlation of growth and IAA production of Lysinibacillus fusiformis ud 270. J. Appl. Phys. 2017, 3, 98–106. [Google Scholar]
- Etesami, H.; Glick, B.R. Halotolerant plant growth–promoting bacteria: Prospects for alleviating salinity stress in plants. Environ. Exp. Bot. 2020, 178, 104124. [Google Scholar] [CrossRef]
- Oliveira, M.M.; Proenca, A.M.; Moreira-Silva, E.; de Castro, A.M.; dos Santos, F.M.; Marconatto, L.; Medina-Silva, R. Biofilms of Pseudomonas and Lysinibacillus marine strains on high-density polyethylene. Microb. Ecol. 2021, 81, 833–846. [Google Scholar] [CrossRef]
- Le, T.-K.; Ju, S.-B.; Lee, H.; Lee, J.-Y.; Oh, S.-H.; Kwon, K.-K.; Sung, B.-H.; Lee, S.-G.; Yeom, S.-J. Biosensor-based directed evolution of methanol dehydrogenase from lysinibacillus xylanilyticus. Int. J. Mol. Sci. 2021, 22, 1471. [Google Scholar] [CrossRef]
- Lee, J.-Y.; Park, S.-H.; Oh, S.-H.; Lee, J.-J.; Kwon, K.K.; Kim, S.-J.; Choi, M.; Rha, E.; Lee, H.; Lee, D.-H.; et al. Discovery and biochemical characterization of a methanol dehydrogenase from Lysinibacillus xylanilyticus. Front. Bioeng. Biotechnol. 2020, 8, 67. [Google Scholar] [CrossRef]
- John, W.C.; Ogbonna, I.O.; Gberikon, G.M.; Iheukwumere, C.C. Evaluation of biosurfactant production potential of Lysinibacillus fusiformis MK559526 isolated from automobile-mechanic-workshop soil. Braz. J. Microbiol. 2021, 52, 663–674. [Google Scholar] [CrossRef]
- Saratale, R.G.; Cho, S.K.; Saratale, G.D.; Ghodake, G.S.; Bharagava, R.N.; Kim, D.S.; Nair, S.; Shin, H.S. Efficient bioconversion of sugarcane bagasse into polyhydroxybutyrate (PHB) by Lysinibacillus sp. and its characterization. Bioresour. Technol. 2021, 324, 124673. [Google Scholar] [CrossRef]
- Kamath Miyar, H.; Pai, A.; Goveas, L.C. Adsorption of malachite green by extracellular polymeric substance of lysinibacillus sp. SS1: Kinetics and isotherms. Heliyon 2021, 7, e07169. [Google Scholar] [CrossRef]
- Narayanan, K.B.; Choi, S.M.; Han, S.S. Biofabrication of Lysinibacillus sphaericus-reduced graphene oxide in three-dimensional polyacrylamide/carbon nanocomposite hydrogels for skin tissue engineering. Colloids Surf. B Biointerfaces 2019, 181, 539–548. [Google Scholar] [CrossRef]

| Species | Origin | Active against | Possible Mechanism | References |
|---|---|---|---|---|
| L. sphaericus | Rice | Rice sheath blight (Rhizoctonia solani) | Induction of systemic resistance, production of antifungal volatile compounds, biosurfactant, HCN, and siderophore | Shabanamol et al., 2017 [41] |
| L. sphaericus | Rice | Rhizoctonia solani | Mycolytic activity | Shabanamol et al., 2018 [41] |
| L. sphaericus | Rice | Nitrogenase activity, IAA production, GA production, CK production, ACC deaminase production | Shabanamolet al., 2018 [41] | |
| L. fusiformis | Apple | Aspergillus nigri, Botrytis cinerea, Phomopsis viticola, and Rhizoctonia solani | Production of antifungal compounds | Passera et al., 2020 [42] |
| Lysinibacillus sp. | Giant bulrush | Pb tolerance, NH3production, IAA production | Kamaruzzaman et al., 2020 [43] | |
| L. sphaericus | Spinach | P solubilization, IAA production, NH3production | Sharma and Shaharan, 2015 [44] | |
| L. fusiformis | Soybean, rice | Nitrogenase activity, IAA production | Park et al., 2005 [45] | |
| L. fusiformis | Chickpea | Fusarium oxysporum, Fusarium solani, and Macrophomina phaseolina | Production of chitinase, protease, and β-endoglucanase | Singhet al., 2013 [46] |
| Lysinibacillus sp. | Rice | IAA production, ACC deaminase production, SA production | Islam et al., 2013 [47] | |
| L. sphaericus | Culture collection | N fixation, nitrification, IAA production | Martínez and Dussán, 2018 [48] | |
| Lysinibacillus | Tea | P solubilization, IAA production, siderophore production, ACC deaminase production | Borah et al., 2019 [49] | |
| Lysinibacillus sp. | Maize | Fusarium verticillioides | Chitinase production | Abiala et al., 2015 [50] |
| Lysinibacillus sp. | Maize | P solubilization, IAA production | Abialaet al., 2015 [50] | |
| L. sphaericus | Undescribed | N fixation | Labuschagne et al., 2015 [51] | |
| L. xylanilyticus | Wheat | NH3production, ACC deaminase production, Zn solubilization | Verma et al., 2014 [52] | |
| L. sphaericus | Wheat | N fixation, IAA production, P solubilization, K solubilization, Zn solubilization | Verma et al., 2016 [52] | |
| L. fusiformis | Ginseng | P solubilization, IAA production, siderophore production | Vendanet al., 2010 [53] | |
| L. fusiformis | Citrus | Candidatus liberibacterasiaticus | Production of salicylic acid and chitinase | Trivediet al., 2011 [54] |
| L. sphaericus | Maize | Alternaria alternata, Curvularia lunata, Aspergillus sp., Sclerotinia sp., Bipolaris spicifera, and Trichophyton sp. | Production of antifungal metabolites, hydrolytic enzymes, and siderophore | Naureen et al., 2017 [55] |
| L. sphaericus | Maize | IAA production, siderophore production, P solubilization, K solubilization, Si solubilization | Naureen et al., 2017 [55] | |
| L. fusiformis | Tomato | No data | Rahmoune et al., 2017 [56] | |
| Lysinibacillus sp. | Compost | Endophytic bacteria Growth promotion under salt stress conditions | Increase in chlorophyll contents of plants, enhancement of antioxidant enzymes in plants | Duo et al., 2018 [57] |
| L. sphaericus | Culture collection | Meloidogyne incognita | Chitinase production | Abdel-Salam et al., 2018 [58] |
| L. sphaericus | Pumpkin | P solubilization | Sule et al., 2020 [59] | |
| Lysinibacillus sp. | P solubilization, IAA production | Sahu et al., 2018 [60] | ||
| L. fusiformis | Argentine screwbean | Endophytic bacteria Growth promotion under salt stress conditions | N fixation, IAA production, GA production, ABA production | Sgroyet et al., 2009 [61] |
| Lysinibacillus sp. | Plant | Endophytic bacteria Growth promotion under salt stress conditions | P solubilization, IAA production, extracellular enzymes production | Kumar et al., 2017 [62] |
| L. varians | Waste contaminated soil | Growth promotion under metal stress conditions of Rhizobacteria | Cd and Pb bio-accumulation, NH3production, IAA production, P solubilization, siderophore production | Pal and Sen Gupta, 2019 [63] |
| L. fusiformis, L. mangiferihumi, | Soil | IAA production, K solubilization, siderophore production | Jinal et al., 2019 [64] | |
| L. fusiformis, L. xylanilyticus | Forest | P solubilization, IAA production | De Mandal et al., 2018 [65] |
Publisher’s Note: MDPI stays neutral with regard to jurisdictional claims in published maps and institutional affiliations. |
© 2022 by the authors. Licensee MDPI, Basel, Switzerland. This article is an open access article distributed under the terms and conditions of the Creative Commons Attribution (CC BY) license (https://creativecommons.org/licenses/by/4.0/).
Share and Cite
Jamal, Q.M.S.; Ahmad, V. Lysinibacilli: A Biological Factories Intended for Bio-Insecticidal, Bio-Control, and Bioremediation Activities. J. Fungi 2022, 8, 1288. https://doi.org/10.3390/jof8121288
Jamal QMS, Ahmad V. Lysinibacilli: A Biological Factories Intended for Bio-Insecticidal, Bio-Control, and Bioremediation Activities. Journal of Fungi. 2022; 8(12):1288. https://doi.org/10.3390/jof8121288
Chicago/Turabian StyleJamal, Qazi Mohammad Sajid, and Varish Ahmad. 2022. "Lysinibacilli: A Biological Factories Intended for Bio-Insecticidal, Bio-Control, and Bioremediation Activities" Journal of Fungi 8, no. 12: 1288. https://doi.org/10.3390/jof8121288
APA StyleJamal, Q. M. S., & Ahmad, V. (2022). Lysinibacilli: A Biological Factories Intended for Bio-Insecticidal, Bio-Control, and Bioremediation Activities. Journal of Fungi, 8(12), 1288. https://doi.org/10.3390/jof8121288

